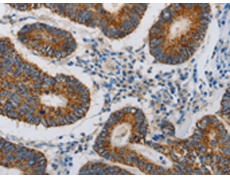
一抗

中文名稱: 兔抗MAP3K5多克隆抗體
英文名稱: Anti-MAP3K5 rabbit polyclonal antibody
別 名: ASK1, MEKK5, MAPKKK5
相關(guān)類(lèi)別: 一抗
儲(chǔ) 存: 冷凍(-20℃)
宿 主: Rabbit
抗 原: MAP3K5
反應(yīng)種屬: Human, Mouse
標(biāo) 記 物: Unconjugate
克隆類(lèi)型: rabbit polyclonal
技術(shù)規(guī)格
|
Background: |
Mitogen-activated protein kinase (MAPK) signaling cascades include MAPK or extracellular signal-regulated kinase (ERK), MAPK kinase (MKK or MEK), and MAPK kinase kinase (MAPKKK or MEKK). MAPKK kinase/MEKK phosphorylates and activates its downstream protein kinase, MAPK kinase/MEK, which in turn activates MAPK. The kinases of these signaling cascades are highly conserved, and homologs exist in yeast, Drosophila, and mammalian cells. MAPKKK5 contains 1,374 amino acids with all 11 kinase subdomains. Northern blot analysis shows that MAPKKK5 transcript is abundantly expressed in human heart and pancreas. The MAPKKK5 protein phosphorylates and activates MKK4 (aliases SERK1, MAPKK4) in vitro, and activates c-Jun N-terminal kinase (JNK)/stress-activated protein kinase (SAPK) during transient expression in COS and 293 cells; MAPKKK5 does not activate MAPK/ERK. |
|
Applications: |
ELISA, IHC |
|
Name of antibody: |
MAP3K5 |
|
Immunogen: |
Synthetic peptide of human MAP3K5 |
|
Full name: |
mitogen-activated protein kinase kinase kinase 5 |
|
Synonyms: |
ASK1, MEKK5, MAPKKK5 |
|
SwissProt: |
Q99683 |
|
ELISA Recommended dilution: |
1000-5000 |
|
IHC positive control: |
Human colon cancer and Human lung cancer |
|
IHC Recommend dilution: |
25-100 |

 購(gòu)物車(chē)
購(gòu)物車(chē) 幫助
幫助
 021-54845833/15800441009
021-54845833/15800441009